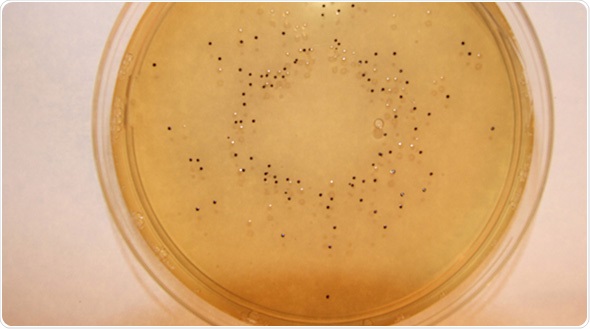

May 8 2015
Following the recent addition of a number of products to the Lab M Listeria testing portfolio, the whole range can now be viewed in a single flyer, available on the Lab M website http://bit.ly/LABM522. The document, ‘Listeria solutions… whatever your method’, clearly shows that whichever testing method users subscribe to, whatever the lab size, and whether they prefer dehydrated culture media (DCM) or a pre-prepared approach, Lab M has products to suit.
Over the last year, Lab M has translated its expertise in developing and manufacturing DCM into a number of convenience products to suit the varying needs of customers, including those without a media kitchen, to help increase efficiencies. µPrep™ Half Fraser Broth ISO (+FAC) is a complete primary enrichment broth designed for use in the isolation of Listeria spp. from foodstuffs, and supplied in ready-to-reconstitute 20 litre bags with no need to autoclave. This means the enrichment broth is ready to use in just 20 minutes. For those who prefer to prepare their own broth, Half Fraser BrothPLUS (ISO), and Fraser BrothPLUS (ISO) are pre-supplemented versions of the ISO media, reducing the preparation steps required and giving flexibility to the volumes prepared. For ultimate convenience, Lab M’s popular Harlequin™ Listeria Chromogenic Agar is also now available as Pinnacle™ pre-poured plates – poured by the manufacturer and followed by a stringent quality management system in a GMP environment.
Although listeriosis is rare, the disease is often severe with high hospitalisation and mortality rates. In the EU about 1,470 human cases were reported in 2011, with a mortality rate of 12.7%. Among vulnerable individuals – pregnant women, elderly people, and those with compromised immunity, for example – the mortality rate can be much higher. Listeria has been isolated from a very wide range of processed foods including pâtés, milk, soft cheeses, ice cream, ready-to-eat cooked and fermented meats, smoked and lightly processed fish products and other seafood. It is also commonly found in the environment, including soil, where it can survive for extended periods.